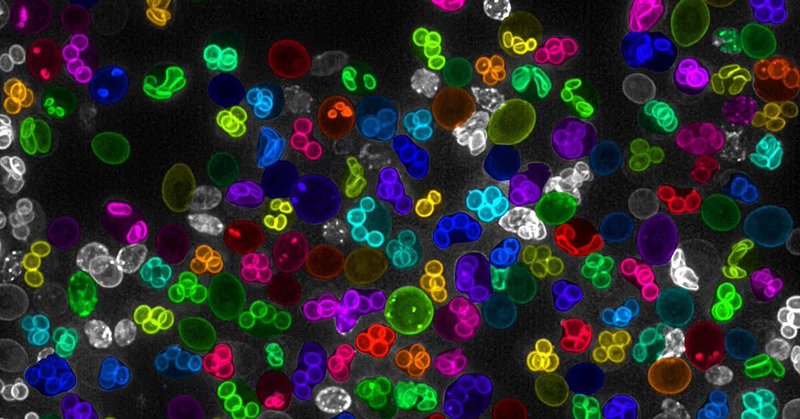
Tweet card summary image

SSBD:database / SSBD:repository
@ssbd_ja
Followers
65
Following
1
Media
11
Statuses
226
SSBDはバイオイメージングデータ、生命科学分野向けの顕微鏡画像や生命動態定量データの共有と再利用のためのプラットフォームです。 English: @ssbd_en
神戸市
Joined December 2017
SSBD: an ecosystem for enhanced sharing and reuse of bioimaging data https://t.co/DEM4CmReB8
@YouTube
0
0
0
プレスリリース|動物の触手は植物の葉と同じルールで配置される? -ヒドロ虫の触手の配置原理と個体サイズによる多型を発見- doi: https://t.co/8CHwfgksSg 詳細はこちらをご覧ください⬇️ https://t.co/tiywEMLBsP #理研プレス #科学道
riken.jp
理研らの共同研究グループは、放射相称動物であるヒドロ虫が体の周りに触手を配置する原理と、個体間に見られる放射相称性の多型を発見し、放射相称の触手配置および種内多型の仕組みを説明する数理モデルを提案しました。
0
25
60
プレスリリース|蛍光タンパク質StayGoldの性能アップ -分子や膜の動態を時空間的に高解像で観察する技術- doi: https://t.co/G6ASoz6XQe 詳細はこちらをご覧ください⬇️ https://t.co/qyXXW4daSy #理研プレス #科学道
riken.jp
理研らの共同研究グループは、蛍光タンパク質StayGoldを改良し、生細胞における分子や生体膜の動態を、蛍光の褪色(たいしょく)の心配なく観察する技術を確立しました。
1
12
40
東北大学の植田先生らとの共同研究成果が@SciReportsに掲載されました。植物受精卵の細胞内構造の極性化に関する報告です。多細胞CREST 研究課題「生命情報の低次元化を起点とする多階層モデル駆動型研究戦略の創出」の成果でもあります。 https://t.co/GHLeEiQFxv
nature.com
Scientific Reports - Comprehensive and quantitative analysis of intracellular structure polarization at the apical–basal axis in elongating Arabidopsis zygotes
0
5
16
老化卵子の染色体数異常を抑止することに成功 -人工動原体による「おとり戦略」の発見- doi: https://t.co/MyUORAxSk0 詳細はこちらをご覧ください⬇️ https://t.co/PuUHqYAwst #理研プレス
riken.jp
老化した卵子の染色体数異常を抑止する技術の開発に成功し、卵子の老化を克服する「人工動原体によるおとり戦略」を提唱しました。
0
48
139
【 #医療・健康 】#AI技術 で重なり合った #細胞膜 を正確に識別・定量する新手法を開発 顕微鏡画像上で重なり合って見える細胞膜を、AI技術を用いて個別に識別し、その形状を正確に定量する新たな手法「DeMemSeg」を開発しました。 https://t.co/CDtoA0BaCz #筑波大学
tsukuba.ac.jp
顕微鏡画像上で重なり合って見える細胞膜を、AI技術を用いて個別に識別し、その形状を正確に定量する新たな手法「DeMemSeg」を開発しました。本手法はこれまで困難であった細胞形態の定量的解析を自動化・高速化するもので、細胞の仕組みの解明や関連疾患の研究を加速させることが期待されます。
0
3
8
"Deep Learning-Based Segmentation of 2D Projection-Derived Overlapping Prospore Membrane in Yeast" https://t.co/HBxdnc5XCG has been published on @CSF_JSCB Congrats! Taguchi-san! SSBD:repository shares the original images of the paper https://t.co/ghxwe9cfmL
jstage.jst.go.jp
Quantitative morphological analysis is crucial for understanding cellular processes. While 3D Z-stack imaging offers high-resolution data, the complex …
0
2
1
【早期公開】3次元画像を2次元に投影するときの問題点を解決しようとする「DeMemSeg」の開発論文です。 Deep Learning-Based Segmentation of 2D Projection-Derived Overlapping Prospore Membrane in Yeast https://t.co/567EvEQak8
0
3
9
ニュースリリース https://t.co/Q41eeFsUxF
riken.jp
理研らの共同研究チームは、ヒト毛周期の時系列的な1細胞遺伝子発現解析手法を開発し、未解明だったヒト毛周期に伴う皮膚組織再構築の分子・細胞メカニズムの一端を明らかにしました。
"Single-cell transcriptomic reconstruction of the human hair cycle: Capturing the temporal dynamics of skin tissue remodeling" https://t.co/qLQBRXzLSC has been published on @CellReports Congrats! SSBD:repository shares the original images of the paper
0
0
0
プレスリリース|ヒト毛周期に伴う皮膚組織再構築の仕組み -1細胞解析により毛周期の時間軸を再構成- doi: https://t.co/YtzvS97ZKP 詳細はこちらをご覧ください⬇️ https://t.co/pEBD8gicGg #理研プレス
riken.jp
理研らの共同研究チームは、ヒト毛周期の時系列的な1細胞遺伝子発現解析手法を開発し、未解明だったヒト毛周期に伴う皮膚組織再構築の分子・細胞メカニズムの一端を明らかにしました。
0
13
31
本研究の内視顕微鏡を用いたデータをSSBD repositoryにdepositしました。 https://t.co/LKrdOlV7pn @ssbd_ja さま、いつもありがとうございます!
0
1
1
microendoscopeの生データ等はSSBDにて公開しております。 https://t.co/7Trz1KOkvp
@ssbd_ja さんいつもありがとうございます!
0
1
0
所属ラボより新作 @ScienceAdvances どぞ( ^^) _旦~~ https://t.co/FkltvzcOQV マウスの眼窩前頭皮質 (OFC) には母性養育行動中に活発に活動する神経細胞があり、これが行動学習の初期に報酬系・VTAドーパミン神経の活動を増強することを明らかにしました。上級研究員・田坂さんの旗艦論文。
science.org
Orbitofrontal cortex neurons facilitate alloparental behaviors in virgin female mice by modulating the dopamine system.
3
17
138
SSBDで共有されているAMATERASの広視野・高精細な画像をぜひご覧下さい https://t.co/r5Y3BCluY7
https://t.co/Al4gxdA8zr
https://t.co/1XqHc6TdgA
2時間番組のトリでした。20分にも渡る尺は初めて。しかも面白くて分かりやすかった。光る植物だけではなく、当初予定になかったAMATERASも紹介してくれた。超優秀な高校生とのご縁も作ってもらえたりといいことずくめの内容に感謝。是非、多くの方にご覧いただきたいなあ。
1
1
1
2時間番組のトリでした。20分にも渡る尺は初めて。しかも面白くて分かりやすかった。光る植物だけではなく、当初予定になかったAMATERASも紹介してくれた。超優秀な高校生とのご縁も作ってもらえたりといいことずくめの内容に感謝。是非、多くの方にご覧いただきたいなあ。
【見逃し配信はこちら📺】 昨日放送された「世界の何だコレ!?ミステリー」で紹介された、永井教授 @Lab_Nagai の #光る植物 に大きな反響をいただき、誠にありがとうございます。 番組を見逃した方は、Tverより配信をご覧いただけます! なお、大阪・関西万博での展示は終了しましたが、
2
4
37
バイオイメージングデータの共有と再利用のためのプラットフォーム「SSBD」@ssbd_ja の新たな紹介動画を公開しました。SSBD:repositoryには学術誌上で発表された全てのバイオイメージング関連データをどなたでも論文発表に合わせて公開することが可能です。 https://t.co/jF5H4mX4EV
0
14
23
なお、この研究で用いられた全ての組織学データ(マウス頭部の連続組織切片データ; 8.5-15.5 dpc)は、理研のSSBD:repository(@ssbd_en)よりダウンロードが可能です。 All histological data head are available on SSBD:repository ! ➡ https://t.co/RUVOQndU4Z
0
4
13
マウス顔面発生大図解論文が出ました。 内容はそう新しくはないんですが、子が生まれたタイミングであまり実験できない代わりに顔面形成について一旦まとめようとか、胚発生って美術系の人に好まれるモティーフの割に資料がないから届いてほしいなとか、色々詰め込みました。🐭 https://t.co/x5JSuvRueT
【プレスリリース】マウス顔面発生大図解:哺乳類の口先は、爬虫類の鼻孔近くの小骨から進化した ■詳細はこちらをご覧ください。 (日) https://t.co/IjtLDmMcPX (ENG) https://t.co/RqfiJvLXdx
1
164
553